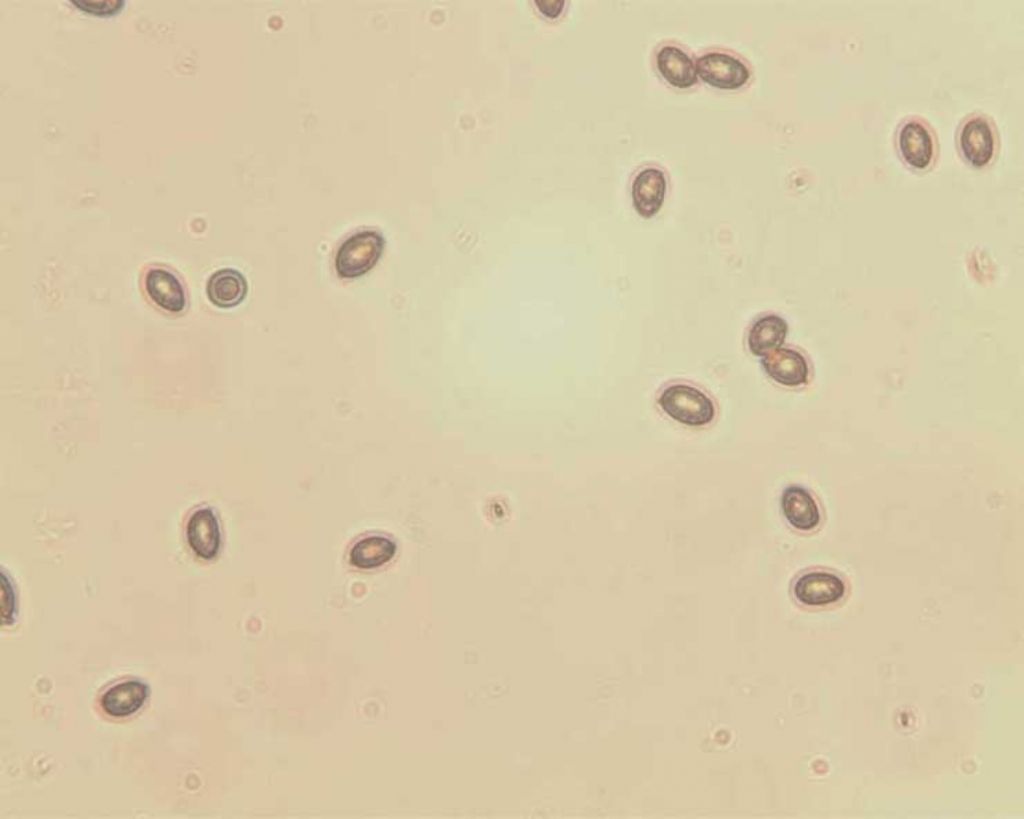

| Autore |
 Discussione Discussione  |
|
georgios
Utente Junior
 
Città: carbonia
Prov.: Cagliari
Regione: Sardegna

44 Messaggi
Tutti i Forum |
|
|
enotria
Utente Senior
   

Città: Gaibanella FE
Prov.: Ferrara
Regione: Emilia Romagna

1322 Messaggi
Tutti i Forum |
 Inserito il - 22 giugno 2015 : 18:58:00 Inserito il - 22 giugno 2015 : 18:58:00


|
Per prima cosa verifica la videocamera che hai acquistato, quasi tutte ormai hanno il programma per le misurazioni. In tal caso dentro la confezione devi trovare anche un vetrino di test per calibrare le misurazioni.
Se ti va male, devi acquistare un oculare micrometrico ed un vetrino di calibrazione. Li puoi trovare usati su eBay o nuovi presso i rivenditori, ma in tal caso sono piuttosto cari (circa 40 Euro ciascuno).
 |
Andrea ---> Link
Ogni oggetto ha la sua storia,
. . . io non vendo oggetti,
. . . . . . io racconto storie. (Enotria) |
 |
|
|
georgios
Utente Junior
 
Città: carbonia
Prov.: Cagliari
Regione: Sardegna

44 Messaggi
Tutti i Forum |
 Inserito il - 22 giugno 2015 : 22:26:14 Inserito il - 22 giugno 2015 : 22:26:14


|
| Messaggio originario di enotria:
Per prima cosa verifica la videocamera che hai acquistato, quasi tutte ormai hanno il programma per le misurazioni. In tal caso dentro la confezione devi trovare anche un vetrino di test per calibrare le misurazioni.
Se ti va male, devi acquistare un oculare micrometrico ed un vetrino di calibrazione. Li puoi trovare usati su eBay o nuovi presso i rivenditori, ma in tal caso sono piuttosto cari (circa 40 Euro ciascuno).

|
mio malgrado la seconda: oculare micrometrico e vetrino di calibrazione.
Gli oculari micrometrici sono standard o devono essere compatibili con la marca del microscopio? Devono essere poi con reticolo o senza reticolo?
grazie
ciao
georgios |
 |
|
|
Aphyllo
Moderatore
    
Città: firenze
Prov.: Firenze
Regione: Toscana

9113 Messaggi
Micologia |
 Inserito il - 22 giugno 2015 : 23:18:20 Inserito il - 22 giugno 2015 : 23:18:20


|
Per tarare la fotocamera basta il vetrino di calibrazione.
Basta usarlo una volta quindi puoi anche fartelo prestare. Comunque credo che se ne possano trovare in commercio anche a 25-30 €.
Procedi fotografando il vetrino con ogni obbiettivo e fai la taratura in pixel/um (numero di pixel per micron) |
 |
|
|
enotria
Utente Senior
   

Città: Gaibanella FE
Prov.: Ferrara
Regione: Emilia Romagna

1322 Messaggi
Tutti i Forum |
 Inserito il - 23 giugno 2015 : 00:01:26 Inserito il - 23 giugno 2015 : 00:01:26


|
Ed allora devi cercare su eBay.
Gli oculari sono standard, ma cercane uno con lo stesso ingrandimento di quelli che usi normalmente, probabilmente un 10x. Normalmente hanno la riga orizzontale suddiviso con tratti da 10 micron, qualcuno ha anche la riga verticale, formando così il classico crocefilo.
Il vetrino serve solo per la taratura, quindi puoi anche fartelo prestare.
Per la calibrazione, tu hai 4 obiettivi, quindi dovrai trovare i 4 coefficienti corrispondenti, in modo da avere il rapporto fra una tacca del vetrino ed una tacca dell'oculare.
Se ad un certo punto decidi di sostituire un obiettivo, ricordati di rifare la calibrazione.
 |
Andrea ---> Link
Ogni oggetto ha la sua storia,
. . . io non vendo oggetti,
. . . . . . io racconto storie. (Enotria) |
Modificato da - enotria in data 23 giugno 2015 00:08:35 |
 |
|
|
georgios
Utente Junior
 
Città: carbonia
Prov.: Cagliari
Regione: Sardegna

44 Messaggi
Tutti i Forum |
 Inserito il - 23 giugno 2015 : 07:32:34 Inserito il - 23 giugno 2015 : 07:32:34


|
ieri sera mi sono accorto che vi è un altro problema che mi sembra insuperabile:volevo scattare delle foto per portarle come esempio ma succede questo: scatto le foto,le foto vengono "catturate" nel senso che si sovrappongono alla visione diretta presente in quel determinato momento all'oculare,ma non riesco proprio a salvarle e perciò vanno perse.
Cosa posso fare? E' un problema di componente mancante nel software (che come detto è indisponibile)?
grazie
ciao
georgios |
 |
|
|
enotria
Utente Senior
   

Città: Gaibanella FE
Prov.: Ferrara
Regione: Emilia Romagna

1322 Messaggi
Tutti i Forum |
 Inserito il - 23 giugno 2015 : 09:19:23 Inserito il - 23 giugno 2015 : 09:19:23


|
Faccio fatica a seguirti, non mi è chiaro quello che dici e vi sono diverse contraddizioni nella tua descrizione.
Comunque, la cosa più logica da fare è contattare il venditore della telecamera e chiedere spiegazioni, ma vedo che non lo fai, immagino avrai i tuoi motivi.
Per lo meno, controlla marca e modello della videocamera, poi vai sul sito del produttore e scarica il driver ed il programma.
Dici che non hai il software, eppure dici che scatti.
Dici che non riesci a salvare la foto, perché ? Dove è finita la foto ? Verifica dove la telecamera registra la foto scattata.
Quando utilizzi la telecamera, sul monitor del PC compare una schermata: fotografala e postala, così vediamo cosa stai usando.
Ad ogni modo, se vuoi farci vedere delle fotografie dei tuoi preparati, basta una semplice compatta, l'appoggi sull'uscita dell'oculare, con lo zoom riempi l'inquadratura e scatti.
 |
Andrea ---> Link
Ogni oggetto ha la sua storia,
. . . io non vendo oggetti,
. . . . . . io racconto storie. (Enotria) |
Modificato da - enotria in data 23 giugno 2015 09:24:12 |
 |
|
|
giancarlo
Moderatore
   
Città: Perugia
Prov.: Perugia
Regione: Umbria

3025 Messaggi
Micologia |
 Inserito il - 23 giugno 2015 : 18:00:23 Inserito il - 23 giugno 2015 : 18:00:23


|
ho seguito la discussione io credo che per risolvere il problema prima di tutto devi riuscire a scattare la foto dalla telecamera e questo è possibile anche con il programma del compiuter se da "risorse del compiuter" puoi vedere la porta dove inserisci la telecamera.
poi facci sapere oppure posta una foto che ti seguiremo passo passo per la misurazione
un saluto a presto |
|
 |
|
|
georgios
Utente Junior
 
Città: carbonia
Prov.: Cagliari
Regione: Sardegna

44 Messaggi
Tutti i Forum |
 Inserito il - 23 giugno 2015 : 23:27:41 Inserito il - 23 giugno 2015 : 23:27:41


|
foto scattata con il 40x
Con un programma scaricato dal web ho verificato che le immagini scattate vengono salvate in "immagini"
Non capisco cosa sia quell'alone che circonda le spore e come fare per le misurazioni
grazie
ciao
georgios
|
 |
|
|
georgios
Utente Junior
 
Città: carbonia
Prov.: Cagliari
Regione: Sardegna

44 Messaggi
Tutti i Forum |
 Inserito il - 23 giugno 2015 : 23:30:17 Inserito il - 23 giugno 2015 : 23:30:17


|
....
Immagine:
33,05 KB |
 |
|
|
enotria
Utente Senior
   

Città: Gaibanella FE
Prov.: Ferrara
Regione: Emilia Romagna

1322 Messaggi
Tutti i Forum |
 Inserito il - 24 giugno 2015 : 00:49:47 Inserito il - 24 giugno 2015 : 00:49:47


|
Come vedi le foto le fa e da qualche parte le memorizza ! 
Dal punto di vista qualità della foto non siamo certo al meglio, ma almeno qualcosina si vede !
L'alone attorno alle spore penso sia della mucillagine, ma io so ben poco di funghi. Piuttosto, se vuoi che i tecnici del Forum ti siano di aiuto, quando metti delle foto, cita almeno la specie che stai fotografando.
Comunque, la foto non è malvagia, hai una illuminazione malfatta, con una dominante rossastra probabilmente data dalla lampada e che puoi eliminare con un filtro azzurro. In più c'è una evidente macchia più chiara in centro data da una cattiva diffusione della luce e che puoi limitare usando un filtro smerigliato.
Per lo meno hai iniziato la tua esperienza in microscopia, ora si tratta di continuare e di migliorare la tua tecnica.
Sei all'inizio di un lungo percorso, ma per lo meno ti stai muovendo.
Buon viaggio ! 
 |
Andrea ---> Link
Ogni oggetto ha la sua storia,
. . . io non vendo oggetti,
. . . . . . io racconto storie. (Enotria) |
 |
|
|
georgios
Utente Junior
 
Città: carbonia
Prov.: Cagliari
Regione: Sardegna

44 Messaggi
Tutti i Forum |
 Inserito il - 24 giugno 2015 : 16:08:39 Inserito il - 24 giugno 2015 : 16:08:39


|
...ma per le misurazioni vorrei sapere se ci sono dei software che si potrebbero scaricare e quale eventualmente mi potete consigliare, oppure devo per forza munirmi di vetrino di tarataura ed oculare micrometrico ??
grazie
le spore son di un cortinarius
|
Modificato da - georgios in data 24 giugno 2015 16:14:06 |
 |
|
|
Aphyllo
Moderatore
    
Città: firenze
Prov.: Firenze
Regione: Toscana

9113 Messaggi
Micologia |
 Inserito il - 24 giugno 2015 : 16:47:26 Inserito il - 24 giugno 2015 : 16:47:26


|
Quell'alone lo vedi anche dagli oculari?
Ti ribadisco che per la taratura della fotocamera serve solo il vetrino di taratura, l'oculare micrometrico non serve |
 |
|
|
georgios
Utente Junior
 
Città: carbonia
Prov.: Cagliari
Regione: Sardegna

44 Messaggi
Tutti i Forum |
 Inserito il - 24 giugno 2015 : 17:38:39 Inserito il - 24 giugno 2015 : 17:38:39


|
| Messaggio originario di Aphyllo:
Quell'alone lo vedi anche dagli oculari?
Ti ribadisco che per la taratura della fotocamera serve solo il vetrino di taratura, l'oculare micrometrico non serve
|
l'alone mi pare di averlo visto anche dagli oculari ma non vorrei sbagliarmi,perciò controllo di nuovo su altre spore.
ciao
georgios |
Modificato da - georgios in data 24 giugno 2015 17:39:33 |
 |
|
|
georgios
Utente Junior
 
Città: carbonia
Prov.: Cagliari
Regione: Sardegna

44 Messaggi
Tutti i Forum |
 Inserito il - 24 giugno 2015 : 22:49:34 Inserito il - 24 giugno 2015 : 22:49:34


|
l'alone è un pò meno evidente guardando direttamente dagli oculari ma nella foto è piuttosto visibile
ciao
georgios
Immagine:

32,69 KB |
 |
|
|
Aphyllo
Moderatore
    
Città: firenze
Prov.: Firenze
Regione: Toscana

9113 Messaggi
Micologia |
 Inserito il - 24 giugno 2015 : 23:08:12 Inserito il - 24 giugno 2015 : 23:08:12


|
| Se si osserva anche dagli oculari probabilmente è un problema di illuminazione. Se mi dici che microscopio è potrei riuscire a capire il tipo di illuminazione e dirti qualche cosa di più preciso... |
 |
|
|
giancarlo
Moderatore
   
Città: Perugia
Prov.: Perugia
Regione: Umbria

3025 Messaggi
Micologia |
 Inserito il - 25 giugno 2015 : 15:04:25 Inserito il - 25 giugno 2015 : 15:04:25


|
benissimo la foto in qualche maniera è arrivata e questo è il primo passo
il secondo passo è quello di procurarti un vetrino micrometrico che poi fotograferai con tutti gli obbiettivi.
a presto con il nuovo compito eh!eh! vedrai che sara facile
un saluto |
|
 |
|
|
georgios
Utente Junior
 
Città: carbonia
Prov.: Cagliari
Regione: Sardegna

44 Messaggi
Tutti i Forum |
 Inserito il - 25 giugno 2015 : 15:19:51 Inserito il - 25 giugno 2015 : 15:19:51


|
il microscopio è Zeiss Primo Star
la video-fotocamera Infinity 1
ciao
georgios
|
Modificato da - georgios in data 25 giugno 2015 15:37:00 |
 |
|
|
georgios
Utente Junior
 
Città: carbonia
Prov.: Cagliari
Regione: Sardegna

44 Messaggi
Tutti i Forum |
 Inserito il - 25 giugno 2015 : 20:49:20 Inserito il - 25 giugno 2015 : 20:49:20


|
| Messaggio originario di giancarlo:
benissimo la foto in qualche maniera è arrivata e questo è il primo passo
il secondo passo è quello di procurarti un vetrino micrometrico che poi fotograferai con tutti gli obbiettivi.
a presto con il nuovo compito eh!eh! vedrai che sara facile
un saluto
|
ok grazie.
Una domanda: il vetrino micrometrico deve avere solo il cerchio oppure cerchio e scala.
Chiedo questa specifica perchè mi pare di aver in commercio vetrini con il solo cerchio (Regno Unito)
ciao
georgios |
 |
|
|
Aphyllo
Moderatore
    
Città: firenze
Prov.: Firenze
Regione: Toscana

9113 Messaggi
Micologia |
 Inserito il - 25 giugno 2015 : 22:21:41 Inserito il - 25 giugno 2015 : 22:21:41


|
| Il reticolo micrometrico dovrebbe stare al centro del cerchio e di solito è di 100 um (micron) che sarebbero 1/10 di millimetro. Forse dalle foto non si vede... |
 |
|
|
georgios
Utente Junior
 
Città: carbonia
Prov.: Cagliari
Regione: Sardegna

44 Messaggi
Tutti i Forum |
 Inserito il - 01 luglio 2015 : 18:04:20 Inserito il - 01 luglio 2015 : 18:04:20


|
..avete qualche link di riferimento da suggerirmi per l'acquisto del vetrino micrometrico di taratura?
ciao
georgios |
Modificato da - georgios in data 01 luglio 2015 18:06:21 |
 |
|
 Discussione Discussione  |
|

 Forum
|
Registrati
|
Msg attivi
|
Msg Recenti
|
Msg Pvt
|
Utenti
|
Galleria |
Map |
Forum
|
Registrati
|
Msg attivi
|
Msg Recenti
|
Msg Pvt
|
Utenti
|
Galleria |
Map |